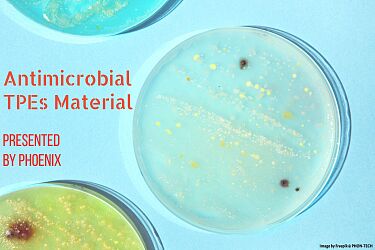
Antimicrobial Thermoplastic Elastomers (TPEs)

PHON TECH INDUSTRIAL COMPANY
- No. 112, Gongye Road, Douliu City, 640153 Yunlin County, Tajwan
- 886-5-5574567
- www.phon-tech.com.tw
Opis
PHOENIX is a fully saturated styrene block copolymer developed by Phon Tech, which contains features of vulcanized rubber at normal temperature and plastics when heated. It means that once they are formed, they can be heated and reformed repeatedly. This property allows for easy processing and facilitates recycling.
Quality is our first and consistent endeavor. Our abundant knowledge, raw materials of high stable quality and strict consistent production offer you the admired goods. All product series of PHOENIX are RoHS compliant, PAHs and phthalates free. Some of the series also conform to FDA or ISO 10993.
PHOENIX has been used in a wide range of markets and applications. The features and benefits of PHOENIX allow the customer to design products without limit. They can be hard or soft. They can bond to a variety of engineering thermoplastics. They can be sleek, silky, opaque, transparent, and colorful. Our expertise makes PHOENIX even more flexible.
Phon Tech can customize the TPE Compounds material that will not only satisfy your requirements but also provide the greatest added value to your products. Phon Tech's R&D team can give guidance and fabricate material based on rich experience and profound knowledge in TPE formulation, compounding, and marketing.
Produkty